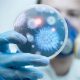

Лекарите предупредуваат на постоењето на нималку наивното внатрешно сало околу виталните органи, дури и кај слабите луѓе. И покрај втемеленото мислење дека нормалната телесна тежина е...


Научниците предупредуваат дека секојдневните домашни работи или нивното избегнување значително можат да го нарушат здравјето на целото семејство! На пример, активностите како перење и готвење неизбежно...


Заборавите на салати она што ви треба за слабеење е сланина, масни сирења и јајца. Еден здравствен гуру открива десет изненадувачки начини на кои може да...


Поради промена на климата и екстремните временски услови храната е сè поотровна предупредуваат научниците. Се произведуваат сè повеќе штетни хемиски соединенија поради приспособување на зачестените екстремни...


Боите имаат силно влијание на нашето расположение и на сите наши сетила. И додека некои нијанси можат да поттикнат добро расположение, да ни отворат апетит или...


Метеоролозите препорачуваат дека треба да внимаваме каде се наоѓаме кога ќе почне да грми. И затоа, доколку по 30 секунди по молњата се слушне удар на...


Стивен Хокинг, еден од најголемите умови на денешнината, но и личност која цел живот се бори со тешката болест на моторните неурони, и наспроти сите животни...


Последните истражувања покажуваат дека лицата што стануваат рано се повити, поздрави и посреќни од тие што сакаат да поспијат подолго. Кетлин Алум, нутриционистка и авторка на...


По избор на новинарот на лондонскиот Индепендент на листата убави зборови на која работат лингвисти „меракот“ е еден од зборовите кои опишуваат нешти убаво, а не...

Американските здравствени работници известија во четвртокот за првиот случај на супербактерија која е отпорна на сите антибиотици, дури и на колистин, кој е лек кој се...